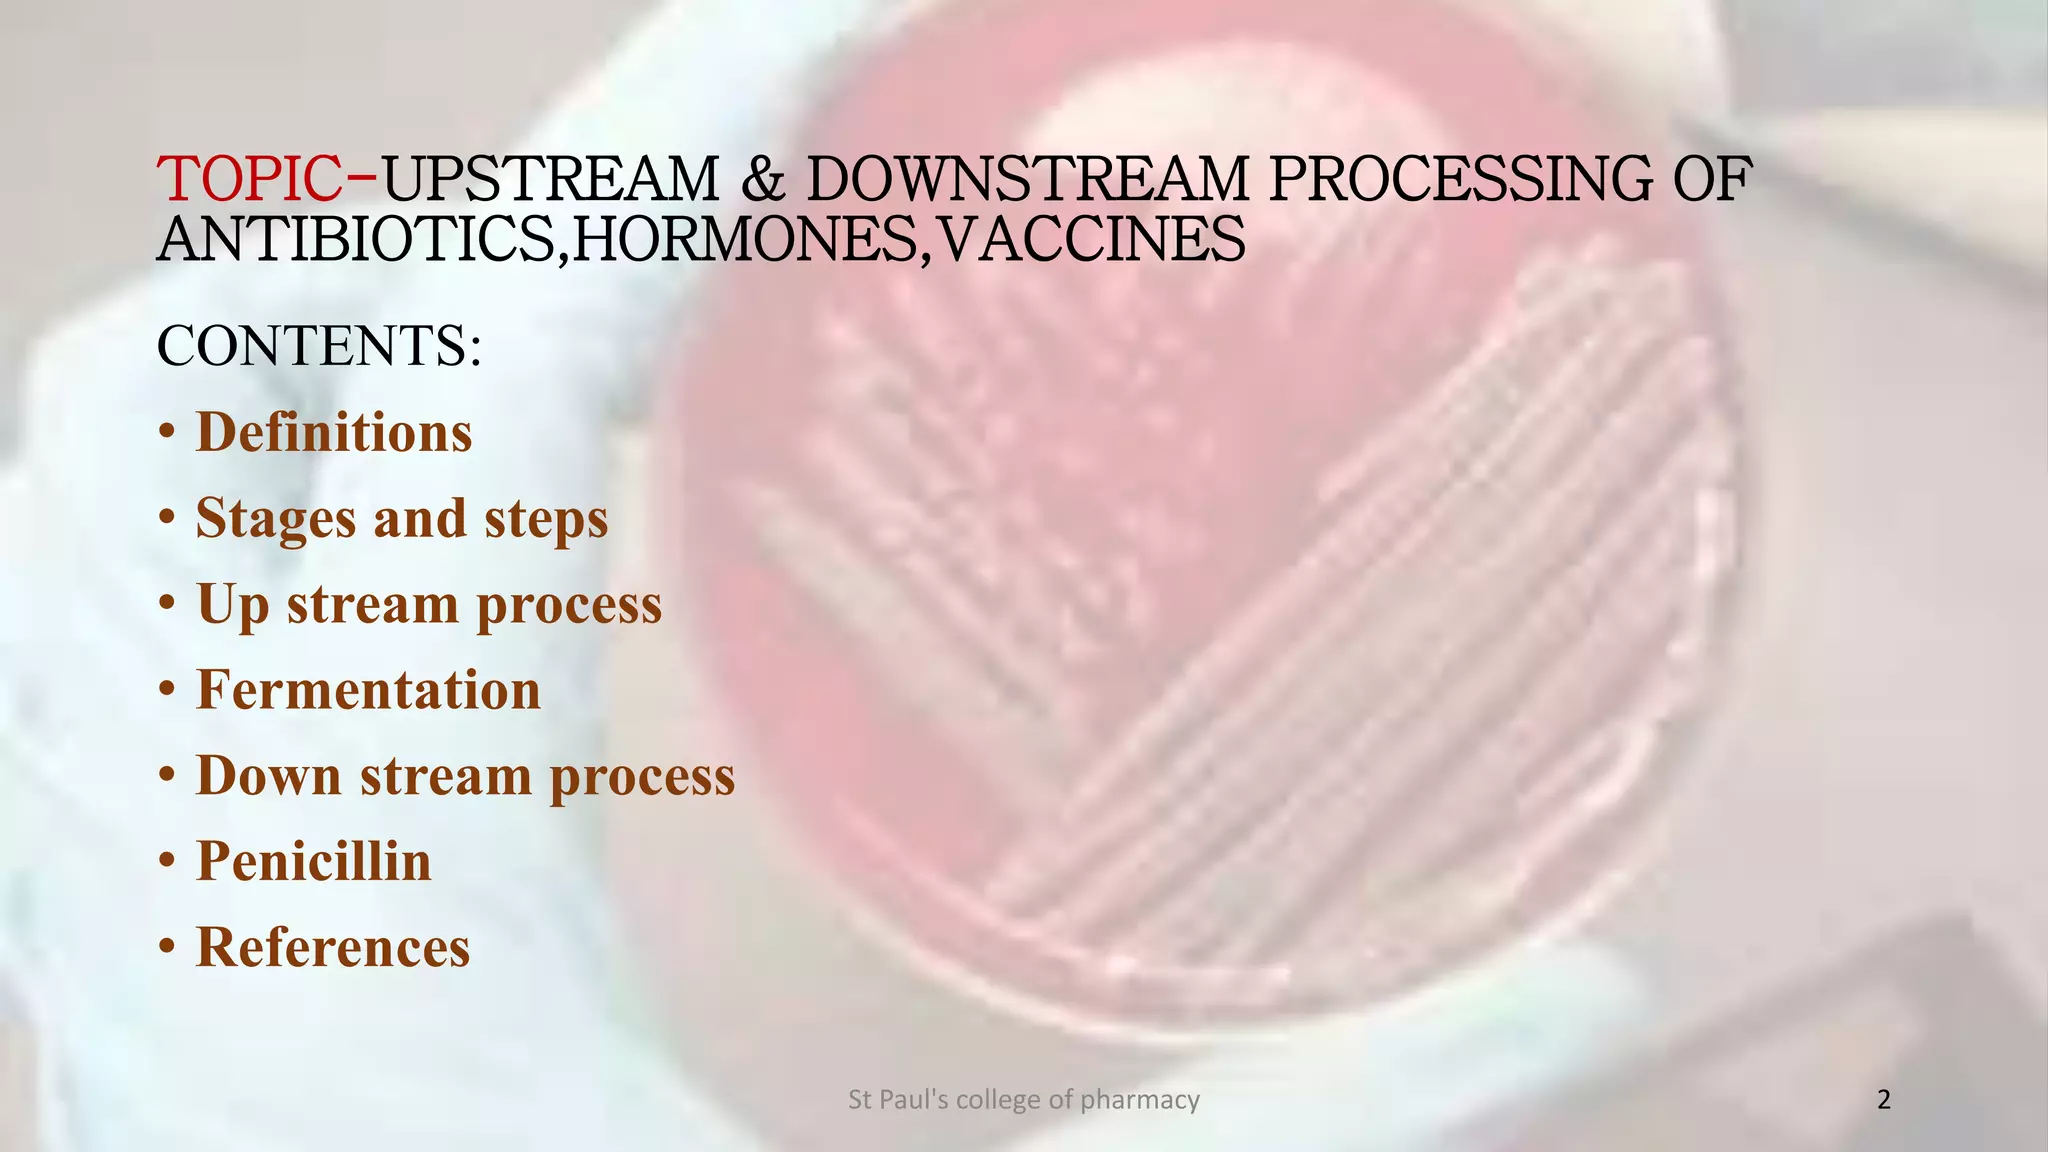
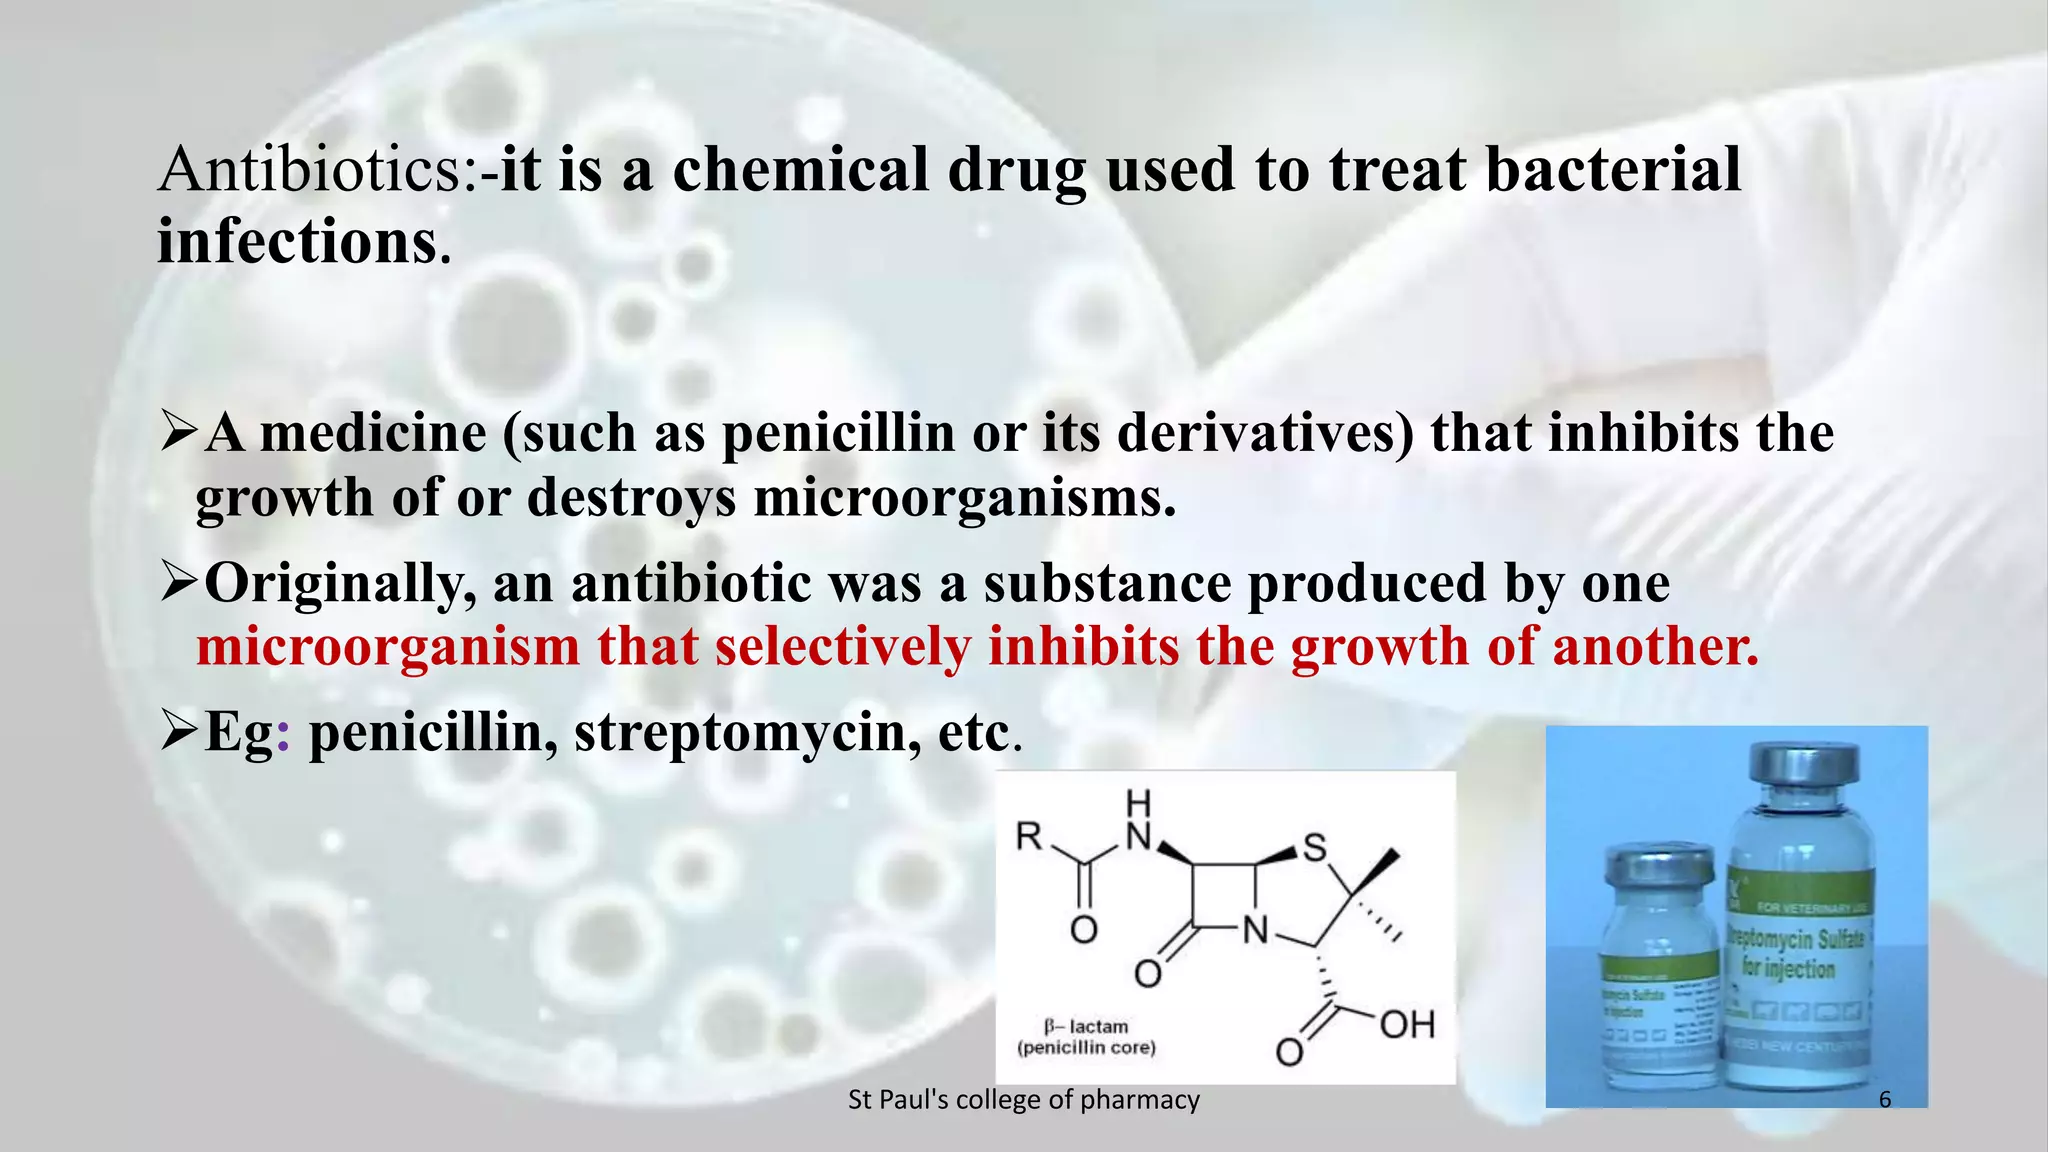
Antibiotics:-it is a chemical drug used to treat bacterial 
infections. 
A medicine (such as penicillin or its derivatives) that inhibits the 
growth of or destroys microorganisms. 
Originally, an antibiotic was a substance produced by one 
microorganism that selectively inhibits the growth of another. 
Eg: penicillin, streptomycin, etc. 
St Paul's college of pharmacy 6
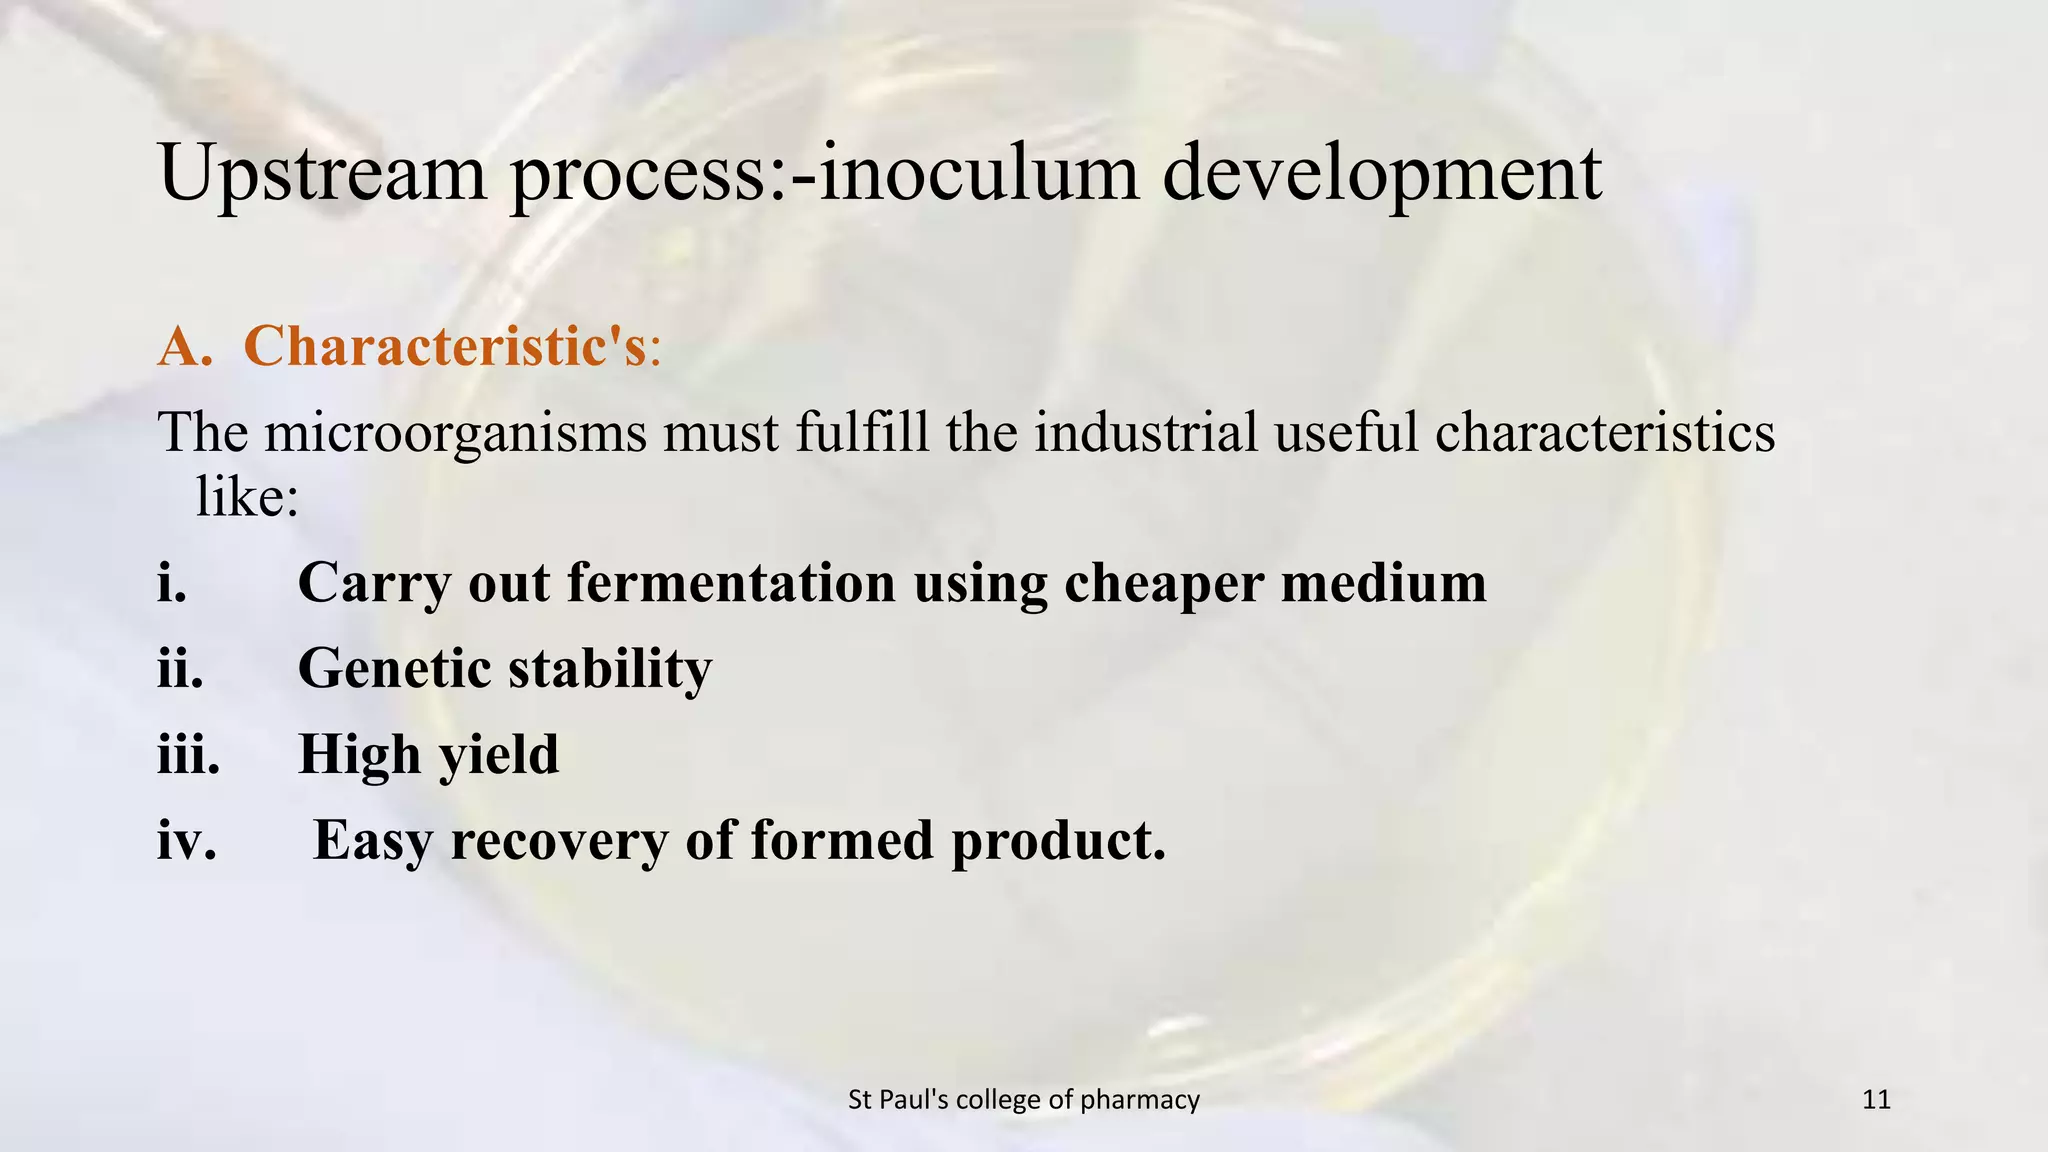
Upstream process:-inoculum development 
A. Characteristic's: 
The microorganisms must fulfill the industrial useful characteristics 
like: 
i. Carry out fermentation using cheaper medium 
ii. Genetic stability 
iii. High yield 
iv. Easy recovery of formed product. 
St Paul's college of pharmacy 11
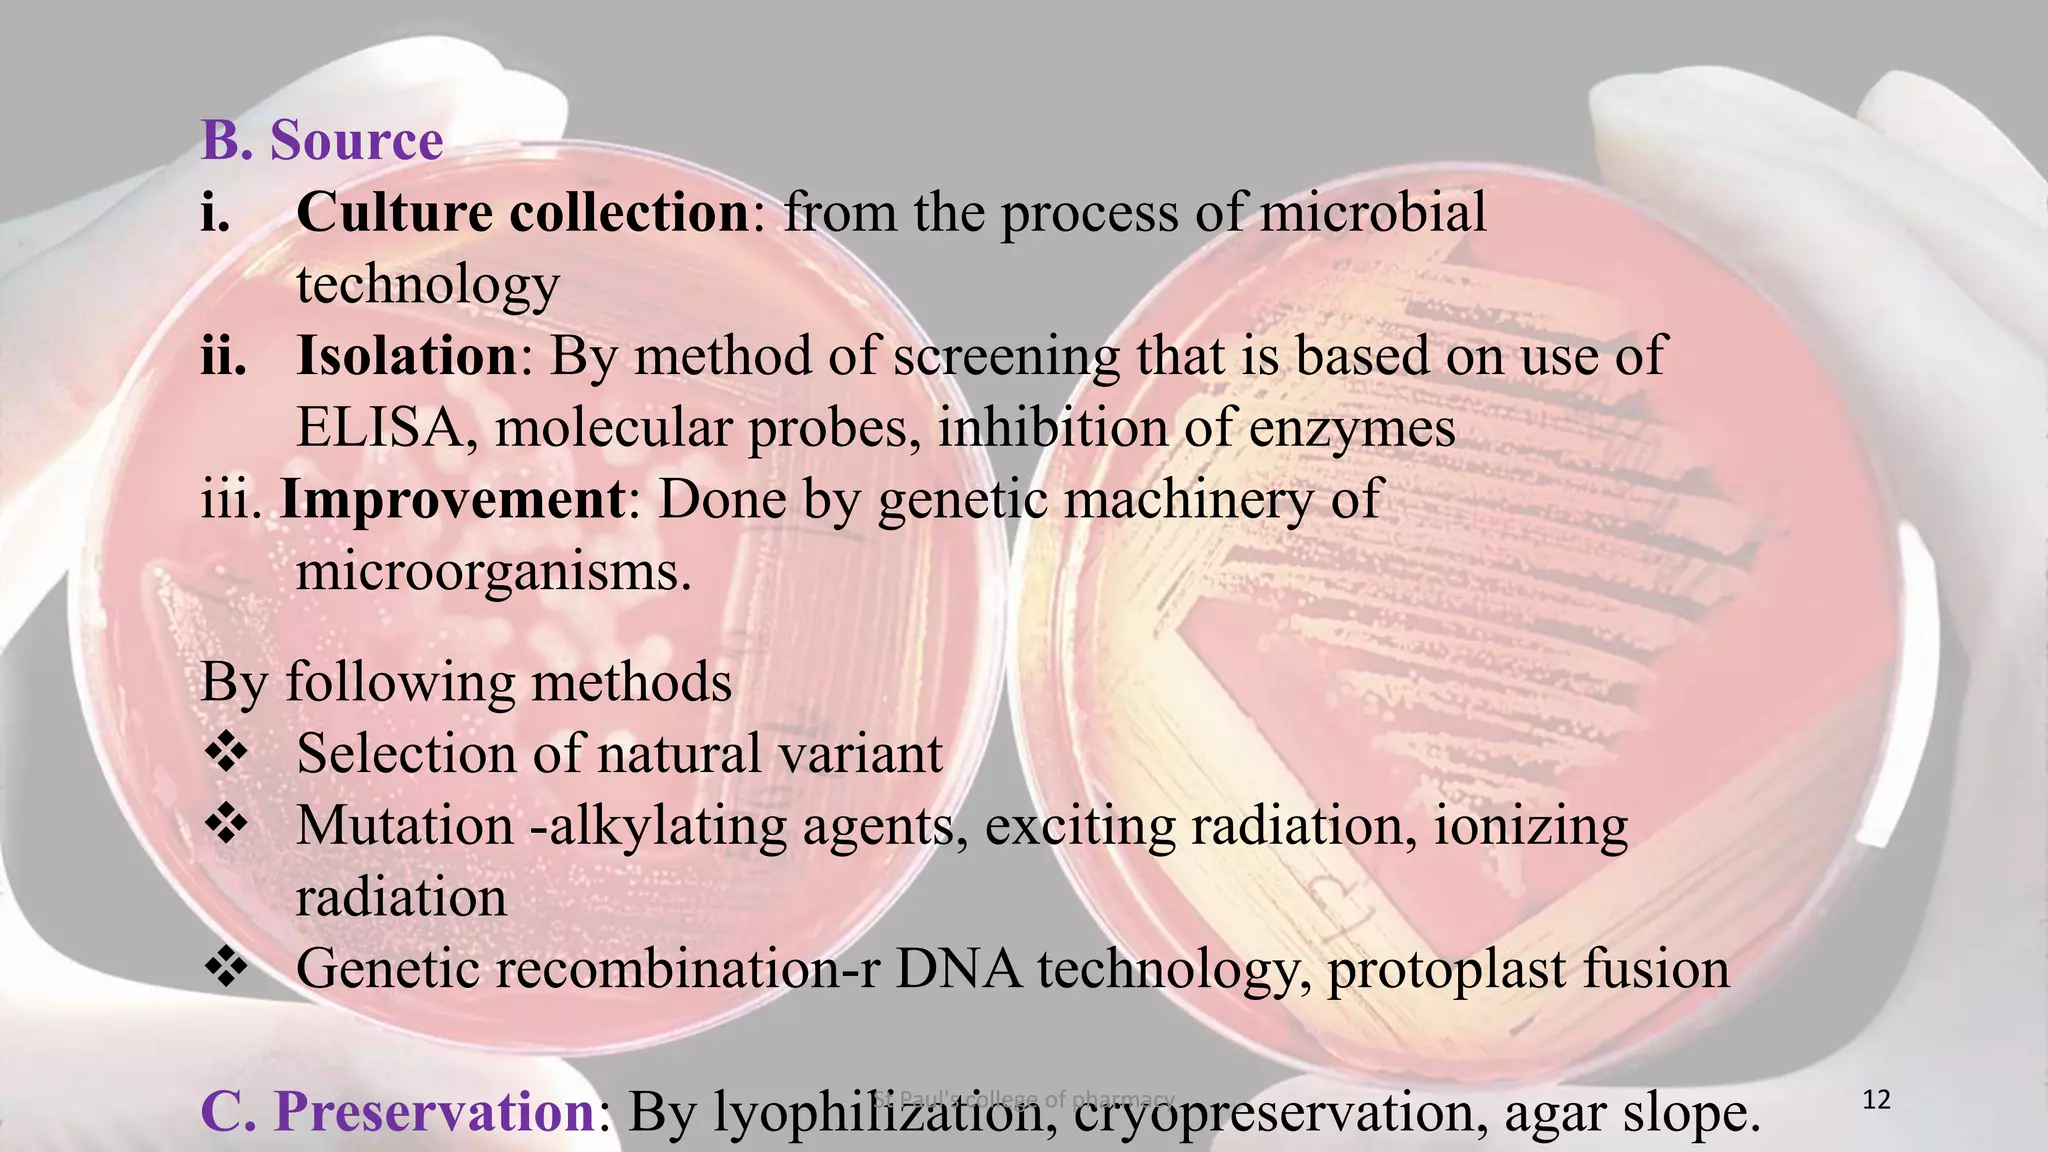
B. Source 
i. Culture collection: from the process of microbial 
technology 
ii. Isolation: By method of screening that is based on use of 
ELISA, molecular probes, inhibition of enzymes 
iii. Improvement: Done by genetic machinery of 
microorganisms. 
By following methods 
 Selection of natural variant 
 Mutation -alkylating agents, exciting radiation, ionizing 
radiation 
 Genetic recombination-r DNA technology, protoplast fusion 
C. Preservation: By lyophilization, cryopreservation, agar slope. St Paul's college of pharmacy 12
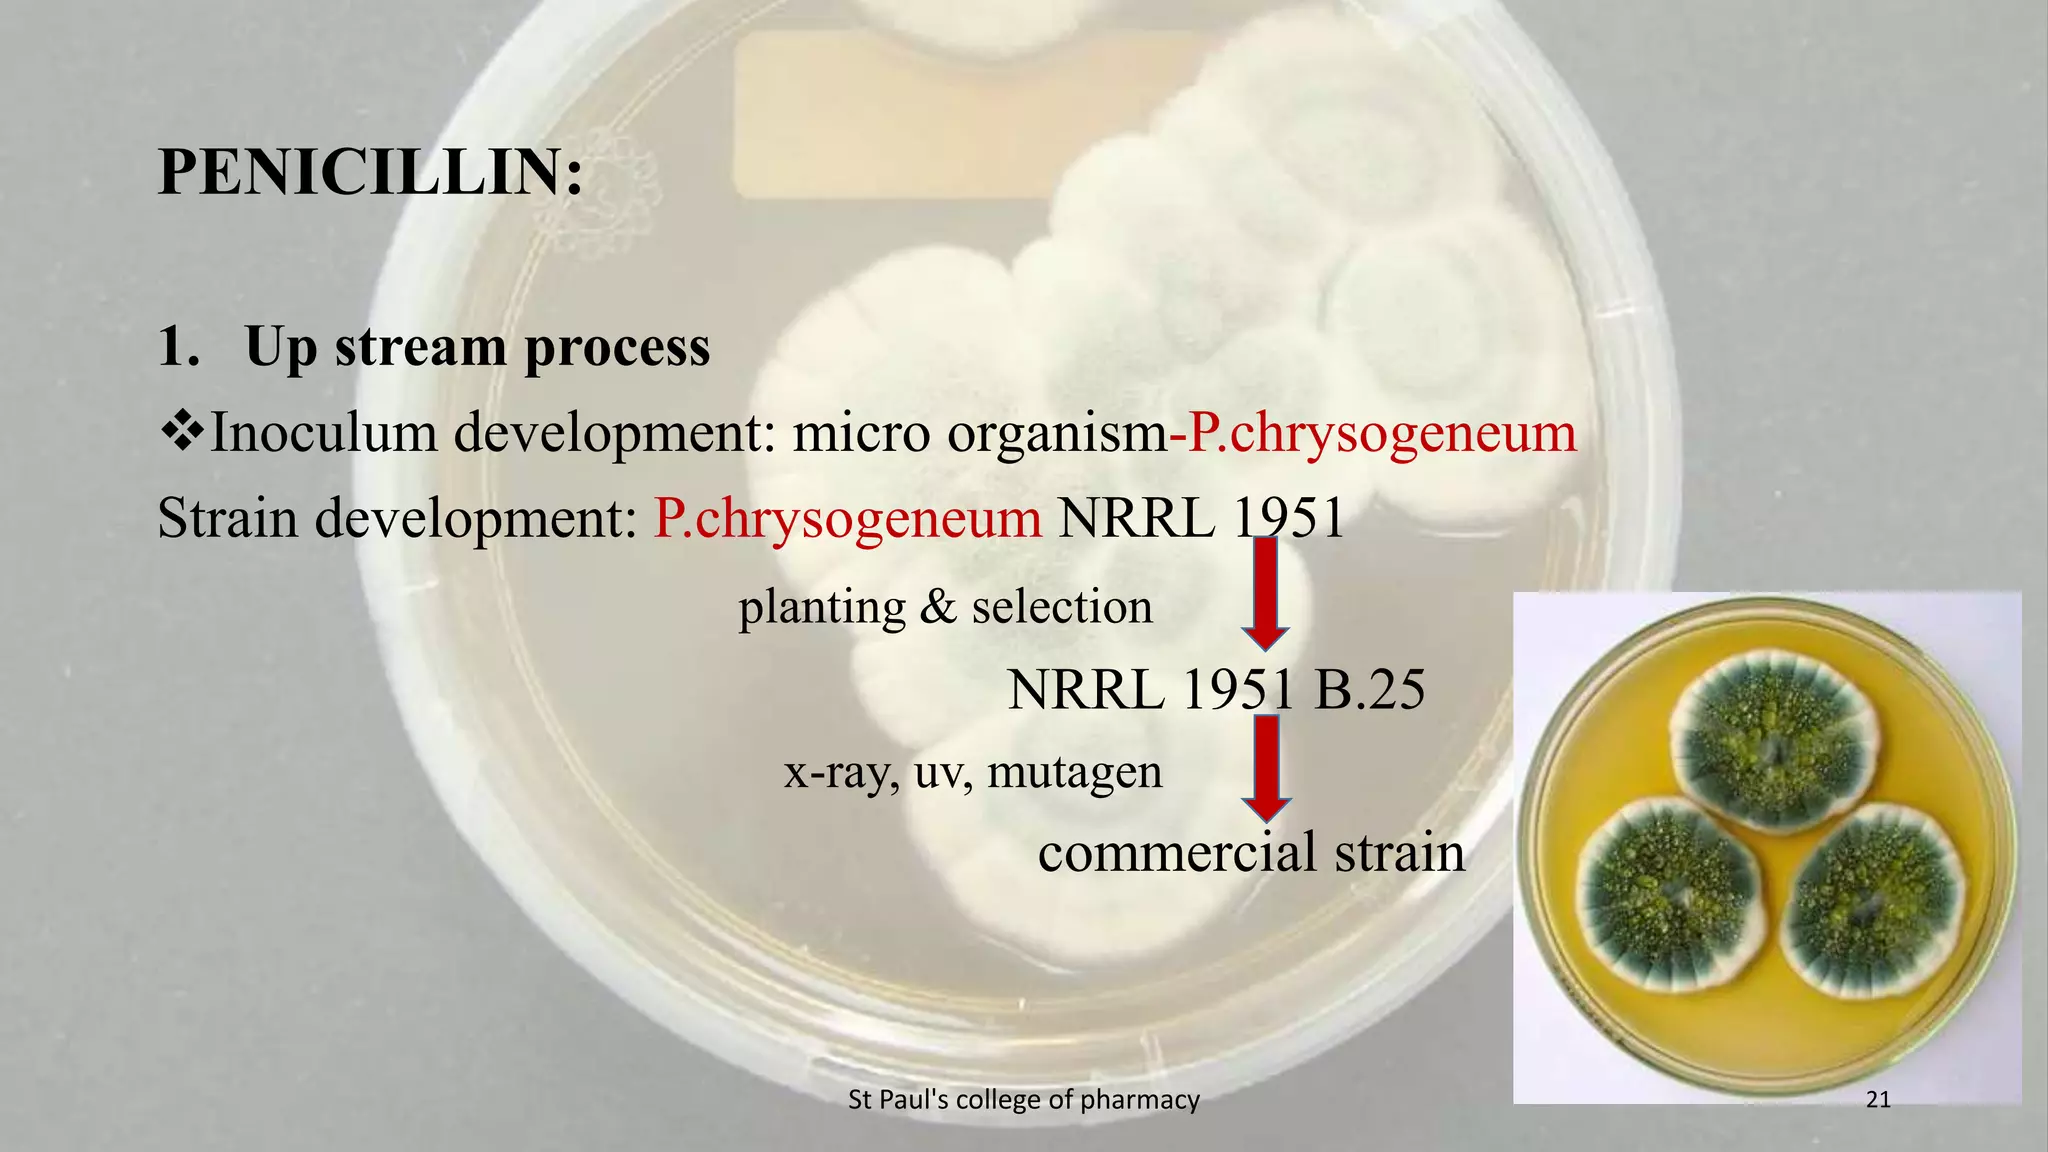
PENICILLIN: 
1. Up stream process 
Inoculum development: micro organism-P.chrysogeneum 
Strain development: P.chrysogeneum NRRL 1951 
planting & selection 
NRRL 1951 B.25 
x-ray, uv, mutagen 
commercial strain 
St Paul's college of pharmacy 21
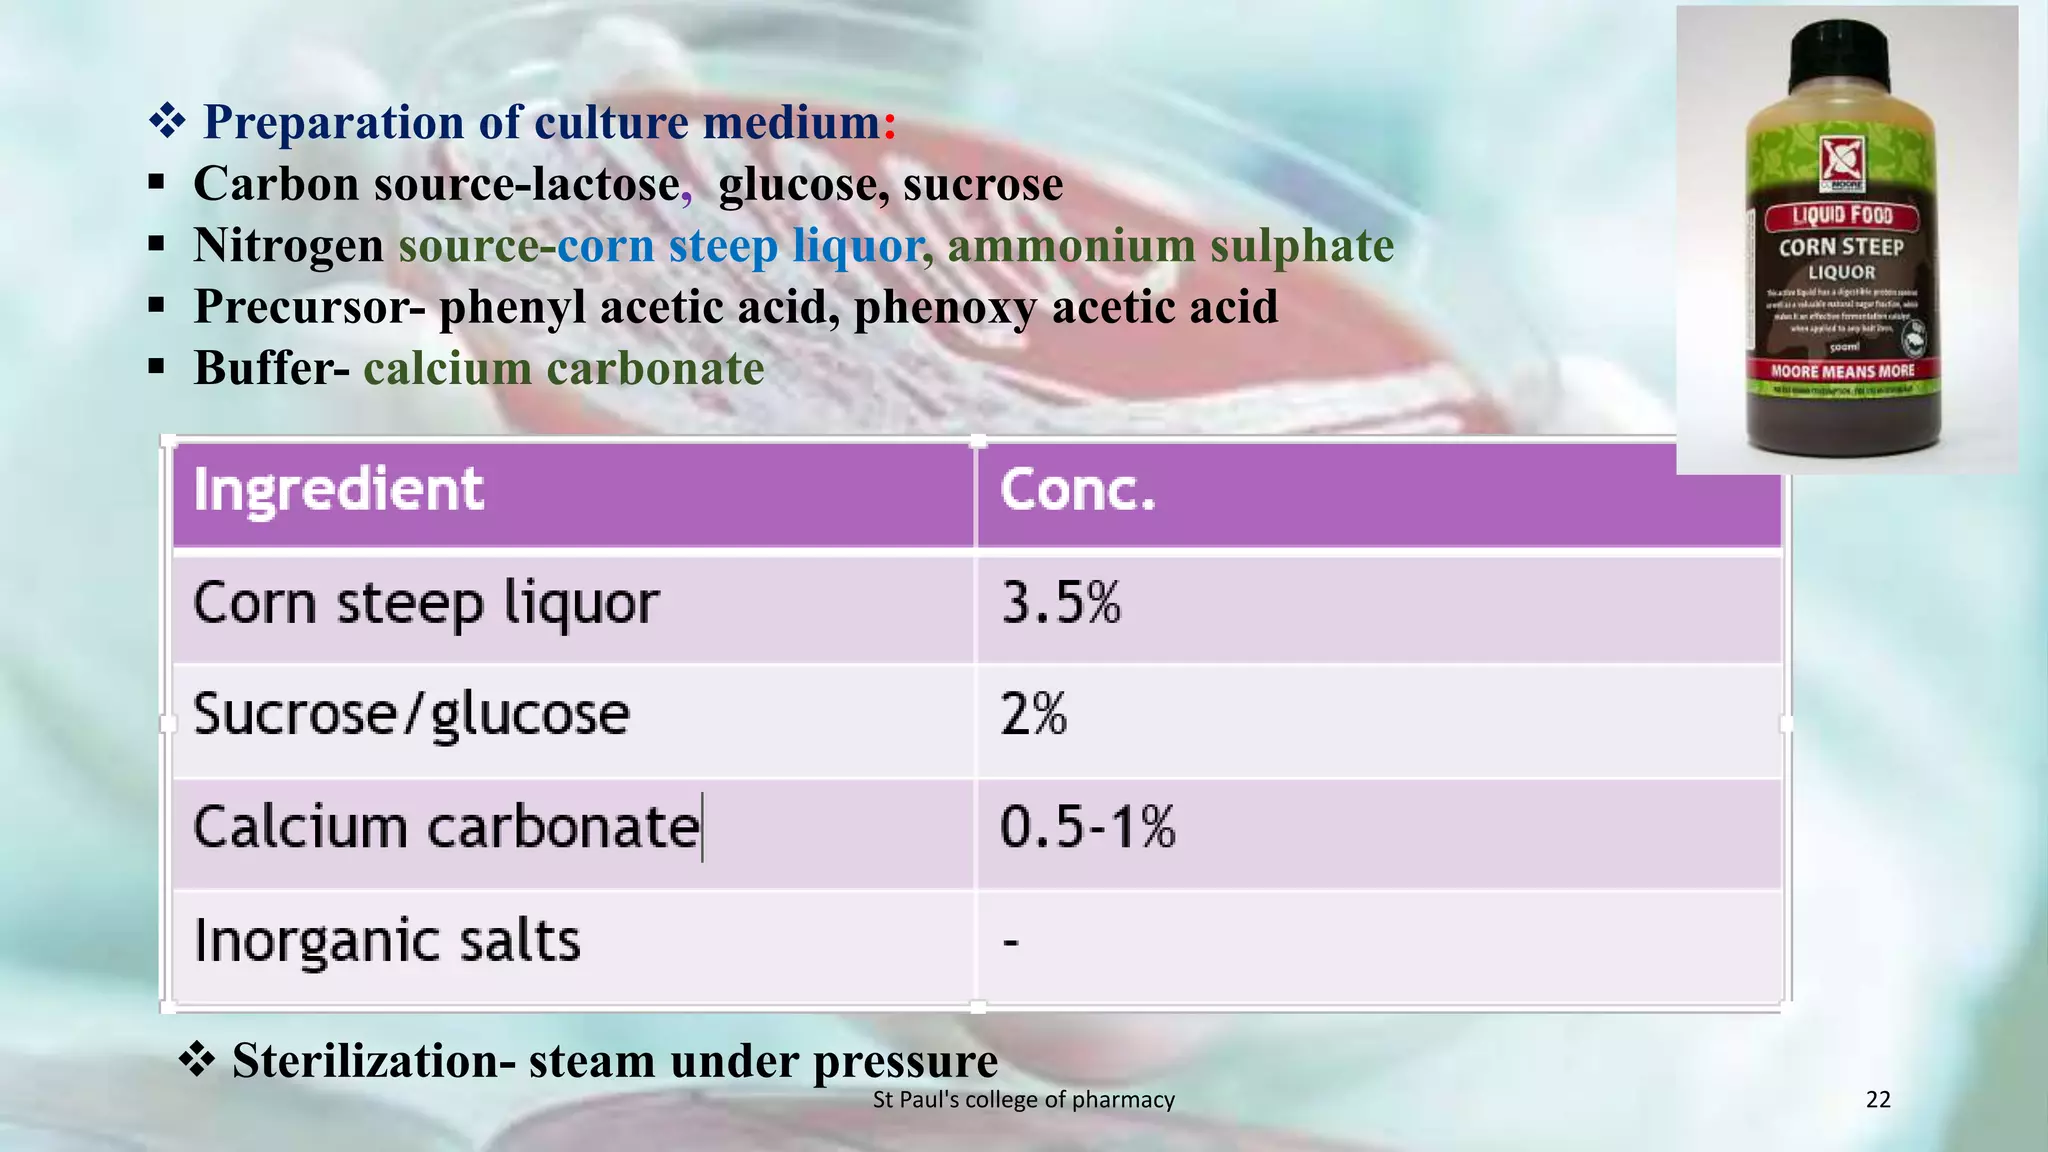
 Preparation of culture medium: 
 Carbon source-lactose, glucose, sucrose 
 Nitrogen source-corn steep liquor, ammonium sulphate 
 Precursor- phenyl acetic acid, phenoxy acetic acid 
 Buffer- calcium carbonate 
 Sterilization- steam under pressure 
St Paul's college of pharmacy 22

The document discusses upstream and downstream processing of antibiotics, hormones, and vaccines. Upstream processing involves fermentation and includes inoculum preparation, culture media development, and fermentation. Downstream processing refers to product recovery, purification, and formulation stages after fermentation. These include steps like separation, concentration, purification. The document provides details of these processes for antibiotics like penicillin, hormones, and vaccines.